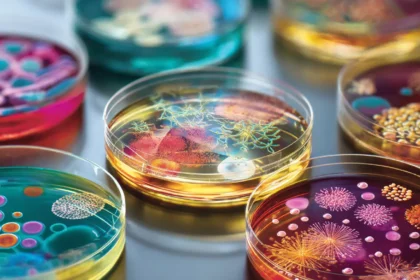

Scopri gli straordinari benefici del cacao. Una guida basata sulla scienza che svela come i flavanoli del cacao possono raddoppiare le cellule staminali....
Scopri come 3 giorni senza smartphone possono rimodellare il tuo cervello: dai cambiamenti nelle aree della ricompensa alla riduzione della dipendenza digitale....
Scopri come le vacanze multiple riducono il burnout del 68% e aumentano energia e felicità. Studi scientifici rivelano i segreti del benessere mentale....
Scopri perché le donne single felici superano gli uomini in benessere. Studio scientifico rivela 7 motivi che cambieranno la tua visione....
Scopri come il microbiota intestinale influenza depressione e ansia. Ricerca 2024 su psicobiotici, asse gut-brain e terapie innovative. Leggi subito! ...
Introduzione I cambiamenti cervello con l’età non sono una semplice parabola discendente: nuove scoperte mostrano un mosaico complesso di perdite, compensazioni e sorprendenti capacità di adattamento....
Introduzione Il termine “benefici canto degli uccelli” può sembrare solo una frase a effetto, ma dietro quelle parole si cela un filone di ricerca che collega l’esperienza sonora della natura al benes...